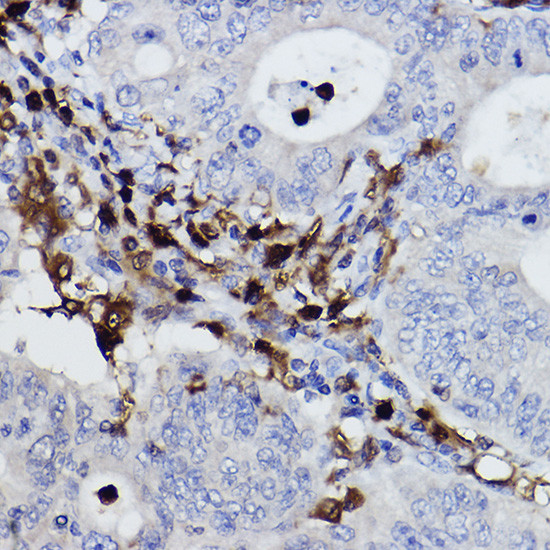
NCF4 Antibody in Immunohistochemistry (Paraffin) (IHC (P))

Search
Invitrogen
NCF4 Recombinant Rabbit Monoclonal Antibody (4L9Z4)
{{$productOrderCtrl.translations['antibody.pdp.commerceCard.promotion.promotions']}}
{{$productOrderCtrl.translations['antibody.pdp.commerceCard.promotion.viewpromo']}}
{{$productOrderCtrl.translations['antibody.pdp.commerceCard.promotion.promocode']}}: {{promo.promoCode}} {{promo.promoTitle}} {{promo.promoDescription}}. {{$productOrderCtrl.translations['antibody.pdp.commerceCard.promotion.learnmore']}}
图: 1 / 4
NCF4 Antibody (MA5-42636) in IHC (P)




Please note: We are reviewing Western blot images included in the antibody testing data in our catalog, including those provided by third parties. Unless expressly labeled or annotated as “raw-unedited”, Western blot images included in the antibody testing data in our catalog may have been edited, optimized or otherwise adjusted for presentation.
产品信息
MA5-42636
种属反应
宿主/亚型
Expression System
分类
类型
克隆号
抗原
偶联物
形式
浓度
规格
纯化类型
保存液
内含物
保存条件
运输条件
RRID
产品详细信息
Positive test controls include: THP-1, Mouse thymus. The target is usually found in the following locations: Cytoplasm, Cytoplasmic side, Endosome membrane, Membrane, Peripheral membrane protein, cytosol.
靶标信息
The protein encoded by this gene is a cytosolic regulatory component of the superoxide-producing phagocyte NADPH-oxidase, a multicomponent enzyme system important for host defense. This protein is preferentially expressed in cells of myeloid lineage. It interacts primarily with neutrophil cytosolic factor 2 (NCF2/p67-phox) to form a complex with neutrophil cytosolic factor 1 (NCF1/p47-phox), which further interacts with the small G protein RAC1 and translocates to the membrane upon cell stimulation. This complex then activates flavocytochrome b, the membrane-integrated catalytic core of the enzyme system. The PX domain of this protein can bind phospholipid products of the PI(3) kinase, which suggests its role in PI(3) kinase-mediated signaling events. The phosphorylation of this protein was found to negatively regulate the enzyme activity. Alternatively spliced transcript variants encoding distinct isoforms have been observed.
仅用于科研。不用于诊断过程。未经明确授权不得转售。
篇参考文献 (0)
生物信息学
蛋白别名: CTA-833B7.1; MGC3810; NCF-4; Neutrophil cytosol factor 4; Neutrophil NADPH oxidase factor 4; OTTHUMP00000028736; OTTHUMP00000043756; p40-phox; p40phox; SH3 and PX domain-containing protein 4
基因别名: NCF4; SH3PXD4
Entrez Gene ID: (Human) 4689